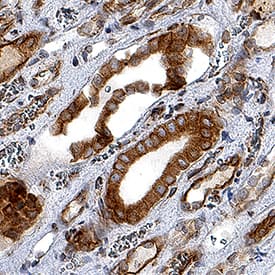
Nox4 antibody in Human Kidney by Immunohistochemistry (IHC-P).

Human Nox4 Antibody
R&D Systems, part of Bio-Techne | Catalog # MAB8158


Key Product Details
Species Reactivity
Validated:
Cited:
Applications
Validated:
Cited:
Label
Antibody Source
Product Specifications
Immunogen
Lys450-Ser578
Accession # Q9NPH5
Specificity
Clonality
Host
Isotype
Scientific Data Images for Human Nox4 Antibody
Nox4 in HUVECs.
Nox4 was detected in immersion fixed human umbilical vein endothelial cells (HUVECs; left panel) using Mouse Anti-Human Nox4 Monoclonal Antibody (Catalog # MAB8158) at 8 µg/mL for 3 hours at room temperature. Cells were stained using the NorthernLights™ 557-conjugated Anti-Mouse IgG Secondary Antibody (red; Catalog # NL007) and counterstained with DAPI (blue). Specific staining was localized to cytoplasm and nuclei. MCF-7 human breast cancer cell line is shown as negative staining (right panel). View our protocol for Fluorescent ICC Staining of Cells on Coverslips.Nox4 in Human Kidney.
Nox4 was detected in immersion fixed paraffin-embedded sections of human kidney using Mouse Anti-Human Nox4 Monoclonal Antibody (Catalog # MAB8158) at 1.7 µg/mL for 1 hour at room temperature followed by incubation with the Anti-Mouse IgG VisUCyte™ HRP Polymer Antibody (Catalog # VC001). Before incubation with the primary antibody, tissue was subjected to heat-induced epitope retrieval using Antigen Retrieval Reagent-Basic (Catalog # CTS013). Tissue was stained using DAB (brown) and counterstained with hematoxylin (blue). Specific staining was localized to cytoplasm and nuclei. View our protocol for IHC Staining with VisUCyte HRP Polymer Detection Reagents.Applications for Human Nox4 Antibody
Immunocytochemistry
Sample: Immersion fixed human umbilical vein endothelial cells (HUVECs)
Immunohistochemistry
Sample: Immersion fixed paraffin-embedded sections of human kidney
Reviewed Applications
Read 1 review rated 5 using MAB8158 in the following applications:
Formulation, Preparation, and Storage
Purification
Reconstitution
Formulation
Shipping
Stability & Storage
- 12 months from date of receipt, -20 to -70 °C as supplied.
- 1 month, 2 to 8 °C under sterile conditions after reconstitution.
- 6 months, -20 to -70 °C under sterile conditions after reconstitution.
Background: Nox4
NADPH Oxidase 4/NOX4, also known as Renal NADPH Oxidase/RENOX and Kidney Oxidase 1/KOX1, is a 66 to 75 kDa member of the NOX family of NADPH oxidases. NOX family members are a major source of reactive oxygen species (ROS), including hydrogen peroxide and superoxide, and are critical mediators of redox signaling. NOX4 is strongly expressed in the kidney, especially in the proximal convoluted tubule cells of the renal cortex, and may function as an oxygen sensor that regulates the synthesis of erythropoietin. Expression is also high in endothelial cells, and because aortas from deficient mice exhibit increased inflammation, hypertrophy and endothelial dysfunction, NOX4 may function to protect the vasculature during ischemic or inflammatory stress. Human NOX4 is 578 amino acids (aa) in length, with several additional smaller isoforms identified. Over aa 450-578, human NOX4 has 92% sequence identity with mouse NOX4, and 91% identity with rat NOX4.
Long Name
Alternate Names
Gene Symbol
UniProt
Additional Nox4 Products
Product Documents for Human Nox4 Antibody
Product Specific Notices for Human Nox4 Antibody
For research use only